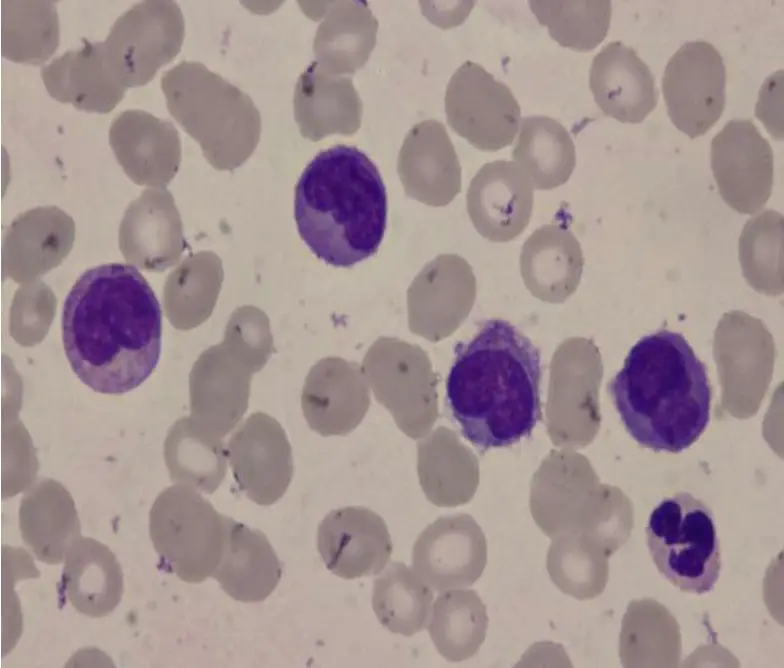
圖片描述

106年:內專
一位72歲病人因為出血傾向及疲倦應診,抽血檢查顯示血紅素為8.2 g/dL,白血球24000/μL,血小板12000/μL;血液抹片如圖所示。這位病人最可能得了何種病?
AChronic myeloid leukemia
BChronic myelomonocytic leukemia
CChronic lymphocytic leukemia
DAcute myeloid leukemia
EAcute lymphoblastic leukemia (ALL)
詳細解析
本題觀念:
慢性骨髓單核細胞白血病(Chronic myelomonocytic leukemia, CMML)屬於 myelodysplastic/myeloproliferative neoplasm overlap 疾病,以持續性血中單核細胞增多(≥1×10^9/L,且單核細胞佔白血球≥10%),伴隨一條或多條血球系統的發育不良,且外周血及骨髓中的 blast+promonocyte <20% 為診斷要件。
影像分析:
從顯微鏡影像可見:
- 大量大小不一之單核細胞,其核呈折疊或腎形,核質較成熟,有核染質聚集而非細碎,細胞質呈灰藍色並可見輕度泡狀空泡,吻合成熟單核細胞或前單核細胞(promonocyte)特徵。
- 其他中性球呈現顆粒減少、核形不規則等發育不良改變。
- 未見大量 Auer 條體或典型 myeloblast。有別於急性白血病的高比例 blasts。
這些影像特徵顯示單核細胞增多,伴隨骨髓造血各系異型,指向 CMML。
選項分析
- 選項A Chronic myeloid leukemia
CML 以顆粒球系全譜增多(嗜中性、嗜酸、嗜鹼球及其前驅細胞),常見 basophilia、myelocyte peak,且需排除 BCR-ABL1 positive;影像並非主要中性球系異常,且無 basophil 增
...(解析預覽)...

升級 VIP 解鎖圖文解析